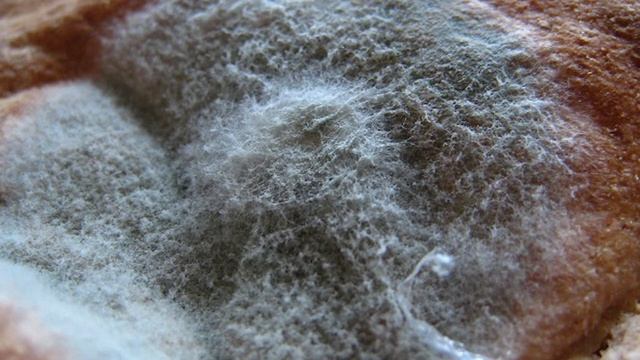

Съела плесень при беременности
Съела плесень при беременности 100 фотографий
Чертежи коробки камаз
Замена двухкамерное окно
Наполи кубок италии
Видео чат 17
Дополнительный андроид на телефон
Народные гуляния ярмарка
Вертекс таблетки производитель
Инверторные морозильники
Сергеевское водохранилище казахстан ситуация на сегодня
Водонагреватель zanussi zwh 80 artendo